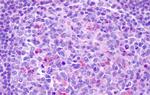
CCR7 Antibody in Immunohistochemistry (Paraffin) (IHC (P))

Search
Invitrogen
CCR7 Polyclonal Antibody
{{$productOrderCtrl.translations['antibody.pdp.commerceCard.promotion.promotions']}}
{{$productOrderCtrl.translations['antibody.pdp.commerceCard.promotion.viewpromo']}}
{{$productOrderCtrl.translations['antibody.pdp.commerceCard.promotion.promocode']}}: {{promo.promoCode}} {{promo.promoTitle}} {{promo.promoDescription}}. {{$productOrderCtrl.translations['antibody.pdp.commerceCard.promotion.learnmore']}}

Please note: We are reviewing Western blot images included in the antibody testing data in our catalog, including those provided by third parties. Unless expressly labeled or annotated as “raw-unedited”, Western blot images included in the antibody testing data in our catalog may have been edited, optimized or otherwise adjusted for presentation.
产品信息
PA5-33401
种属反应
宿主/亚型
分类
类型
抗原
偶联物
形式
浓度
规格
纯化类型
保存液
内含物
保存条件
运输条件
RRID
产品详细信息
Percent identity with other species by BLAST analysis: Human, Gorilla, Gibbon, Monkey, Marmoset, Bat, Bovine, Horse (100%) Mouse, Rat, Hamster, Elephant, Panda, Dog, Rabbit, Pig (94%).
靶标信息
CCR7 is a member of the G-protein-coupled chemokine receptor family with seven membrane-spanning domains and functions as a receptor for 6Ckine/SLC (secondary lymphoid-tissue chemokine), CCL19 and CCL21. CCR7 has been shown to be internalized via clathrin-coated pits and the majority recycled back to the plasma membrane. CCR7 is expressed on T cells and can be used to distinguish populations of naive from central and effector memory T cells. CCR7 has been shown to play a role in migration of memory T cells to inflamed tissue. Expression of CCR7 is also found on DC's. During DC maturation CCR7 expression increases and is thought to be involved in a variety of functions: chemotaxis to the lymph node, cellular architecture, rate of endocytosis, survival and maturation.
仅用于科研。不用于诊断过程。未经明确授权不得转售。
生物信息学
蛋白别名: BLR2; C-C chemokine receptor type 7; C-C CKR-7; C-C motif; CC-CKR-7; CCR-7; CD197; CDw197; chemokine (C-C motif) receptor 7; EBI1; Epstein-Barr virus-induced G-protein coupled receptor 1; MIP-3 beta receptor
基因别名: CCR7; CMKBR7; EBI1; EVI1
Entrez Gene ID: (Bovine) 510668, (Horse) 100067673




